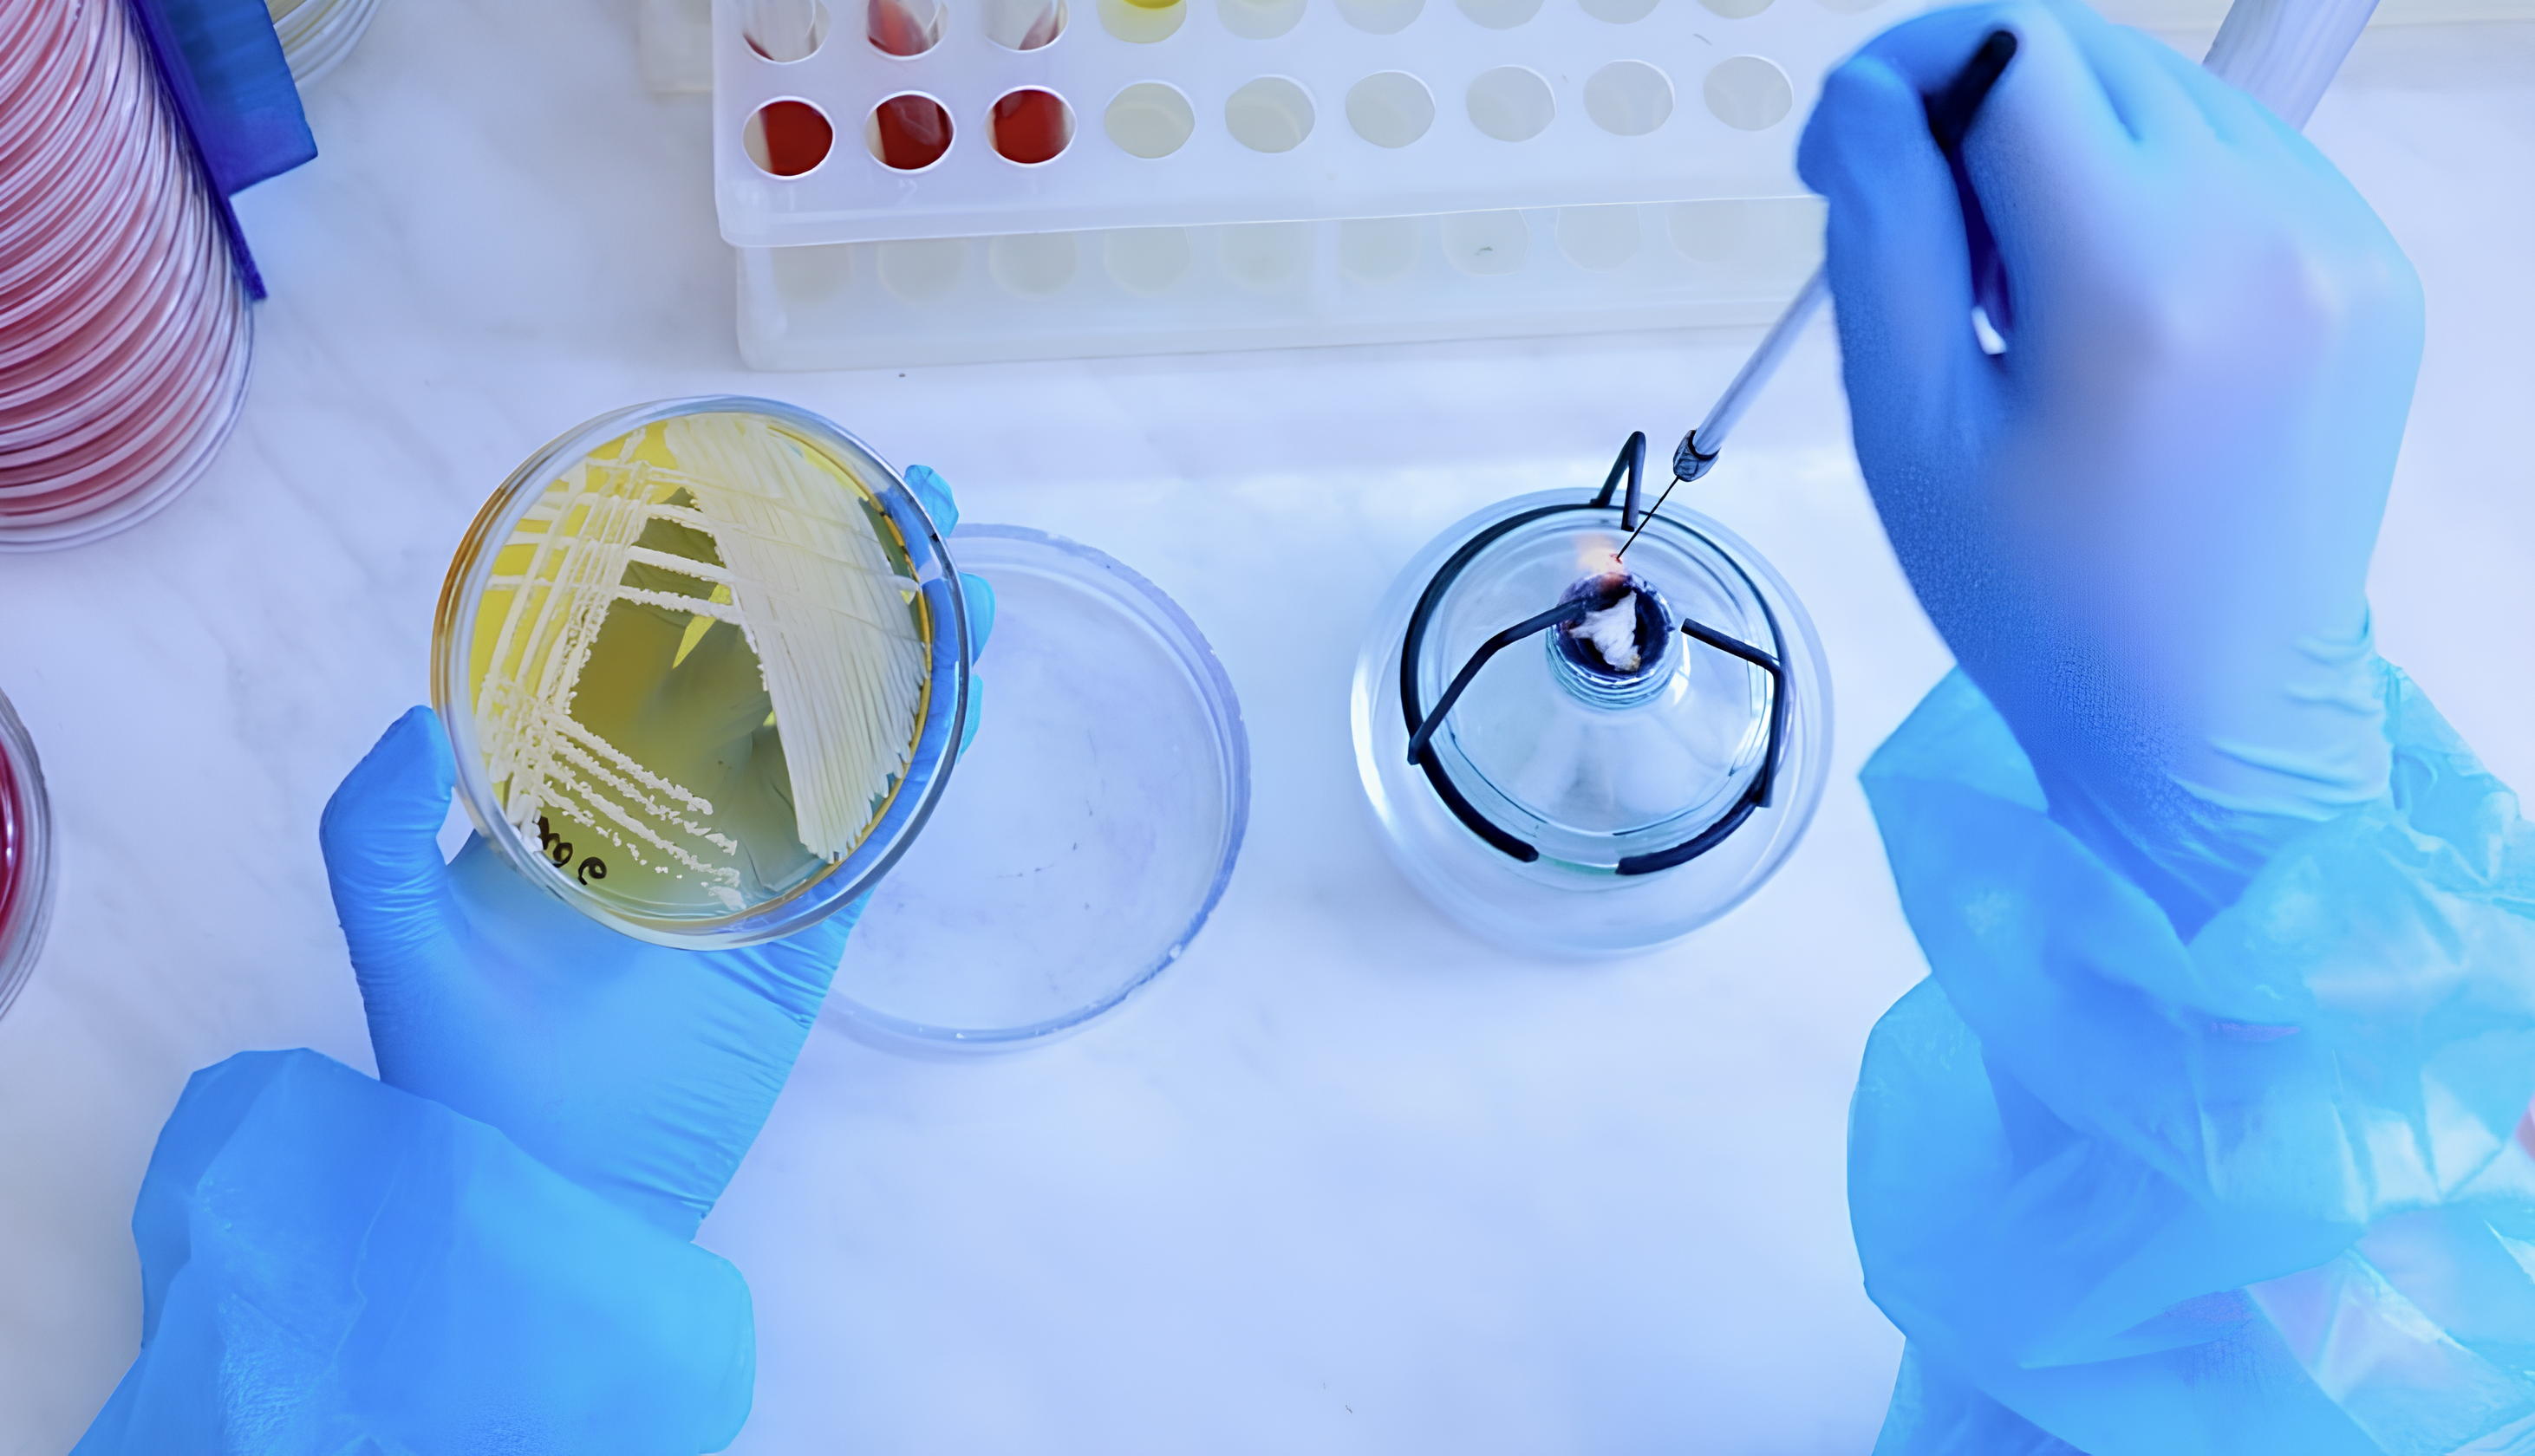

Микроорганизмы, проводящие весь жизненный цикл при температурах окружающей среды выше 45 °С, называются термофилами. «Обычные» микроорганизмы не могут жить в подобных условиях из-за того, что у них разрушаются белки, рассказали специалисты Федерального исследовательского центра «Фундаментальные основы биотехнологии» РАН (ФИЦ Биотехнологии РАН).
Ферменты (белки-катализаторы, способствующие протеканию реакций в любом живом организме) широко используют в медицине, в частности, для проведения анализов (например, обнаружения вируса COVID-19), входят в состав пятновыводителей, моющих средств, продуктов фармацевтической и пищевой промышленности, добавили ученые. Многие промышленно значимые ферменты производятся именно термофилами.
Коллектив ученых ФИЦ Биотехнологии РАН совместно с коллегами из Российского государственного университета нефти и газа имени И.М. Губкина обнаружил и описал условия культивирования и генетический материал бактерии Tenuifilum osseticum, которая сбраживает простые сахара (глюкозу, мальтозу), полисахариды (крахмал, ксилан, ламинарин) и белки (пептон, желатин, казеин) без доступа кислорода с образованием уксусной кислоты, водорода и углекислого газа.
«Бактерия имеет ряд общих черт с ранее описанным нами видом Tenuifilum thalassicum. Они обе термофильны, имеют форму тонких палочек, живут без кислорода, перерабатывают органические молекулы и вырабатывают типичные жирные кислоты для этого рода. Но Tenuifilum osseticum растет при более узком диапазоне температур и более широком диапазоне солености. Последнее особенно удивительно, поскольку новый вид выделен из пресноводного источника, тогда как его родственник обитает в морских гидротермах», ― рассказала руководитель проекта, старший научный сотрудник лаборатории метаболизма экстремофильных прокариот ФИЦ Биотехнологии РАН Ольга Подосокорская.
Специалист добавила, что исследователи не обнаружили генов, отвечающих за формирование жгутиков, однако нашли гены скольжения. При этом классического скольжения у клеток не наблюдалось, лишь изредка в неблагоприятных условиях можно было заметить слабые подергивания.

Верхние Кармадонские источники, откуда была выделена новая бактерия Tenuifilum osseticum. Источник: Мария Прокофьева
По мнению ученых, новый вид бактерий является перспективным организмом для биотехнологий из-за неприхотливости к солености, которая упрощает и удешевляет процесс культивации Tenuifilum osseticum в промышленных условиях.
Если вы хотите стать героем публикации и рассказать о своем исследовании, заполните форму на сайте РНФ.

